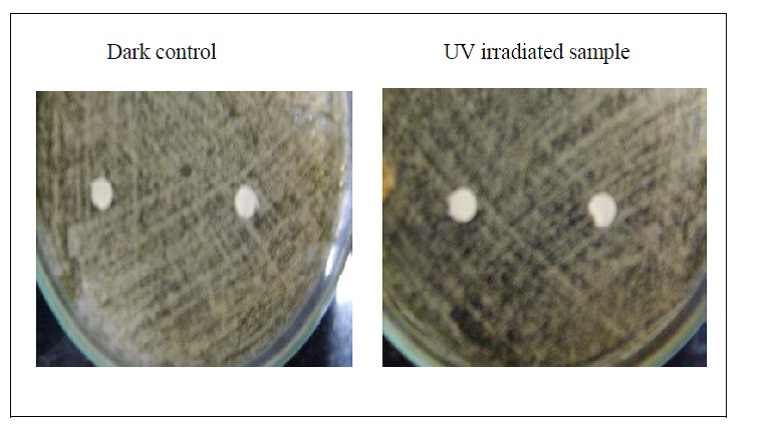
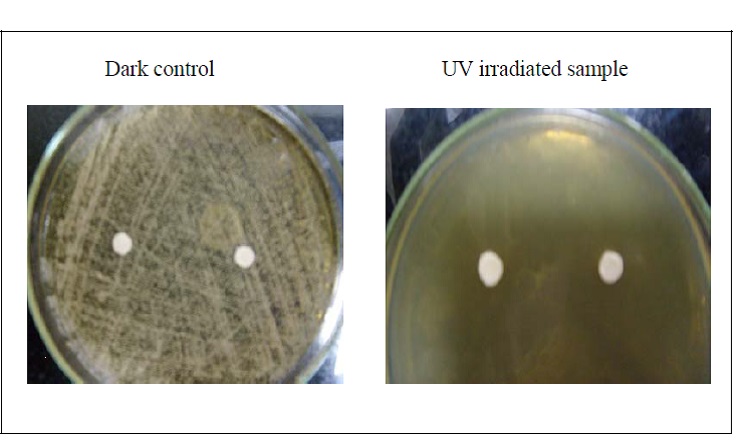
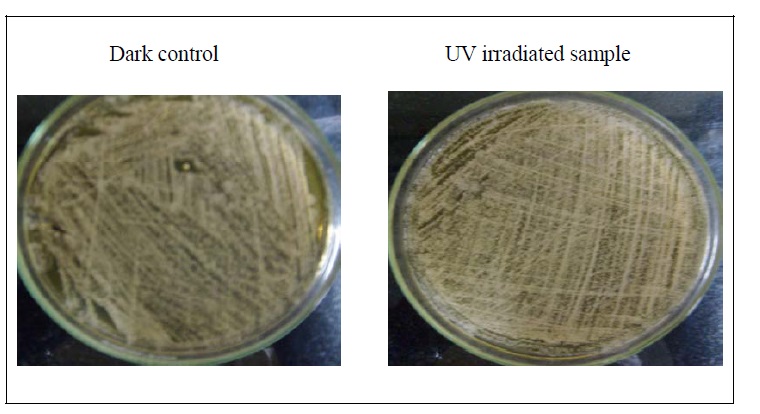

Int J Pharm Pharm Sci, Vol 6, Issue 11, 41-45Original Article
IN VITRO PHOTO-TOXICITY SCREENING OF HYDROALCOHOLIC EXTRACT OBTAINED FROM MANILKARA ZAPOTA (L.) ROYEN LEAVES
NORMA LEONARD REBELLO*1,2, SUHASINI SHYAMKANT BHALERAO
1Shri JagdishPrasad Jhabarmal Tibrewala University, Jhunjhunu, Rajasthan, India , 2St. John Institute of Pharmacy and Research, Manor Road, Palghar, District Thane-401404, Maharashtra, India.
Email: normasjipr@gmail.com
Received: 10 Sep 2014 Revised and Accepted: 08 Oct 2014
ABSTRACT
Objective: Cosmetic products like sunscreens are being used widely nowadays due to increasing consumer awareness about the harmful effects of ultraviolet light exposure. Conventionally used chemical filters lack photostability hence produce skin reactions. The present research thus aims to evaluate the photostability of the hydro-alcoholic extract obtained from the leaves of Manilkara zapota (L.) Royen, Sapotaceae, a potential sunscreen using in vitro phototoxicity assays.
Methods: Leaves of the plant was extracted using hydroalcoholic solvent (water: ethanol, 3:7) by maceration technique. Candida albicans lawn seeded Sabouraud dextrose agar plate, impregnated with test extract soaked filter paper disc was irradiated at a dose 0.2 mW/cm2 for 4 hours. Absorption spectra of known concentration of the test extract at initial as well on irradiation was measured and compared with standards. Linoleic acid peroxidation test was used to determine the extent of peroxides formed using TBARS assay.
Results: Candida yeast test revealed that there was no photodegradation metabolites of the extract formed on irradiation thus growth of the Candida albicans remained unaffected. Spectra measurement studies revealed no significant change in the spectrum in the wavelength 250-320 nm of M. zapota extract however the standard phototoxic compound showed a significant change. Linoleic acid peroxidation test revealed a very limited peroxide formation 6.47 μmoles/ ml comparable with the standard Quercetin, Gallic acid and marketed sunscreen formulation.
Conclusion: All the in vitro phototoxicity assays concluded that the hydroalcoholic extract obtained from Manilkara zapota (L.) Royen leaves exhibited photostability to the Ultraviolet irradiation.
Keywords: Manilkara zapota (L.) Royen, Hydro-alcoholic, UV radiation, Phototoxicity, Candida yeast, Lipid peroxidation.
INTRODUCTION
Cosmetic Industry is blooming day by day due to constant consumer demand. One of the widely used products is the sunscreens. These products prevent or minimize the harmful effects of the solar radiations on the skin. Ultraviolet radiations (UVR) or solar radiations are electromagnetic radiations with wavelength in the range of 200 nm - 400 nm. Prolong exposure to UVR has pronounced acute and chronic effects on the skin. Over the long term exposure, degenerative changes in the skin cells, fibrous tissues, blood vessels, leading to premature ageing, photodermatoses, inflammation, in most serious cases skin cancers could also erupt [1]. The conventionally used sunscreens have been relooked nowadays with respect to photostability, major concern considering overexposure to UVR as cause of global warming. Photo instability leads to phototoxic reactions, wherein the photo labile molecule absorbs energy from UV light and releases it into the skin. Further phototoxic response occurs either by formation of photo adducts with biomolecules or through generation of reactive oxygen species (ROS), including singlet oxygen (1O2) and superoxide (O2-) which selectively modify various oxidative reaction mechanisms [2]. Several adverse reactions have been reported during the last decades against chemical sunscreen agents. Cinnamate derivatives (Octyl-Methoxycinnimate), one of the most widely used chemical ultraviolet B (UVB) filter in sunscreen products have shown undesirable reactions such as allergy, photoallergy, reactive oxygen species production and estrogenic activities [3]. In addition to the external insults the skin also has to cope with endogenous ROS and other free radicals produced during physiological cellular metabolism. Although synthetic antioxidants like butylated hydroxyl toluene (BHT) and butylated hydroxyl anisole (BHA) are commonly used in processed foods and cosmetics, they are reported to have undesirable effects on body cells and are in controversies since last three decades [4, 5]. This may explain the interest in examining plant extracts as a source of natural, cheap, safe and effective antioxidant sunscreens.
Manilkara zapota (L.) Royen also called as sapota, or chikoo plant belongs to the family Sapotaceae. It is an evergreen, glabrous tree, growing upto 8-15 m in height. It is cultivated throughout India (most extensive in coastal India such as Maharashtra, Gujarat, Andhra Pradesh, Madras and Bengal States), although being native to Mexico and Central America. Antimicrobial [6] and antioxidant activities are also reported using the ethanolic extracts of leaves [7], seeds [8] and bark [9]. Alcoholic and acetone extract of M. zapota (L.) Royen leaves have been reported to reveal the presence of flavonoids as well as phenolic compounds like apigenin-7-O-α-L-rhamnoside, myricetin-3-O-α-L-rhamnoside and caffeic acid [10]. Formulations of sunscreens mostly contain compounds which are effective UV light absorbers or having photoabsorbtive properties. Flavonoids are one such constituent and natural substances extracted from plants like green tea polyphenols, Aloe barbadencis extract and aromatic compounds isolated from lichens have been considered as potential sunscreen resources on similar grounds [11]. Ethanolic extract of M. zapota leaves also possess antioxidant activity due to the presence of flavonoids and polyphenolic constituents [12,7]. Although sunscreen activity of the hydroalcoholic extract of M. zapota leaves have been determined, its photostability is yet to be determined. Thus the present research aimed to evaluate the photostability of the M. zapota leaves extract using simple in vitro phototoxicity assays.
MATERIALS AND METHODS
Plant material
Fresh leaves of Manilkara zapota (L.) Royen Sapotaceae, were collected from the local garden of Palghar (St. John Technical Campus) District Thane, Maharashtra, India. Leaves of the plant were separated, cleaned, shade dried, coarsely grinded and stored in air tight containers. The plant was further authenticated by Dr. Harshad Pandit, Head of the Department of Botany, G. N. Khalsa College of Arts, Science and Commerce, Matunga, Mumbai and the specimen no. # nlr 080314 is deposited in the Herbarium of the Department.
Extraction
The shade dried leaves of the plant were extracted by maceration technique. Coarsely grinded leaves were taken in the conical flask, hydro-alcoholic solvent (water and ethanol mixture, 3:7) was added to wet the powder. Further sufficient solvent was added and the flask was sonicated using a bath sonicator. Flask was further kept on orbital shaker for the specified time at 80-90 rpm for complete maceration. Macerated slurry was filtered using vacuum. Filtrate, thus obtained was concentrated by evaporation of the solvent to get the dried extract. The liquid extracts were further subjected to the preliminary phytochemical screening to determine the phytoconstituents.
In vitro screening of phototoxicity of the extract
Candida yeast test
Freshly prepared and autoclaved Sabouraud dextrose agar (Himedia®) was allowed to cool at 55°C. The agar was added to glass petridishes and allowed to solidify. One hour later, plates were seeded with 0.2 mL of a culture of Candida albicans in Sabouraud dextrose broth containing approximately 105cells/ml. Whatman filter paper discs impregnated with test solutions (M. zapota extract and marketed formulation) were placed on C. albican lawn and left for another 30 mins. Duplicate plates were set up, one serving as a dark control and other test plates being exposed to UV radiation from an array of fluorescent tubes (obtained from KJ. Enterprizes) within a wavelength 250-370 nm at an irradiance dose of about 0.2 mW/cm2 for 4 hours at room temperature. At the end of the exposure all the test plates as well as the dark control plates were incubated at 25°C for 48 hours. Phototoxicity was indicated by a clear zone around the test material in the irradiated cultures, while growth in the dark controls was unaffected. Candida albicans seeded on Sabouraud dextrose agar served as negative control whereas filter paper discs impregnated with the marketed formulation served the positive control [13].
Irradiation Dose (J/cm2) = Irradiation time (Secs) x Intensity of light (μW/s)
Photostability study using spectra measurement
An initial UV spectrum of test extract of known concentration was taken and exposed to UV radiation as follows. 5 mL each samples, Manilkara zapota leaves extract and standards Para amino benzoic acid (PABA), Benzophenone respectively was placed in colorless glass vials and irradiate sideways at 24°C ± 1°C from a fixed distance of 10 cm using a UV lamp (obtained from KJ. Enterprizes) within a wavelength 250-370 nm at an appropriate irradiance dose 0.2 mW/cm2. At time intervals of 0 min, 1, 3, and 5 hrs, an aliquot of 1 ml was withdrawn from the vial. The samples were further diluted and the spectrum on Shimadzu UV 1800 double beam UV-visible spectrophotometer was taken. The difference in the spectra indicated the extent of photodegradation [modified procedure as per 14].
Photosensitized peroxidation of Linoleic acid
Standardization of malondialdehyde (MDA) concentration
10 mM stock solution of MDA was prepared by adding 1 mmol of 1,1,3,3-tetraethoxypropane to 100 mL of 1 % v/v of sulphuric acid. The mixture was left at room temperature for 2 hrs to achieve complete hydrolysis. The stock was further diluted to about 1-10 μM. The absorbance of the solution was taken at 245 nm. A molecular extinction coefficient of 13700 was used to calculate the concentration of malondialdehyde in the solution.
![]()
0.3 mL of different concentrations of MDA solutions (1-10 μM) were mixed with 1 mL of 0.67 % w/v thiobarbituric acid (TBA) dissolved in phosphate buffer saline pH 7.4 and 10 μL of 1.0 % w/v butylated hydroxyl toluene (BHT) solution in glacial acetic acid. The mixture was incubated at 95º C for 60 minutes. After cooling under tap water, it was further extracted with 1 mL of 1-butanol. The mixture was centrifuged at 4000 rpm for 10 minutes. The absorbance of the organic layer (upper layer) was read at 532 nm on Shimadzu UV 1800 double beam UV-visible spectrophotometer. A standard curve was prepared correlating the concentration of MDA in the solutions used and the absorbance of the pink colored complex obtained by reaction with TBA.
Procedure
Linoleic acid (1 mM), suspended in phosphate buffer saline pH 7.4 containing 0.05 % w/v Tween 20, was irradiated at 30,000 lx in the presence of test compound (1%w/v), and lipid peroxidation was measured using a TBA assay as described previously. To the irradiated sample (500 μL), 1 mL of 0.67 % w/v TBA dissolved in phosphate buffer saline pH 7.4 and 10 μL of 1.0 % w/v BHT solution in glacial acetic acid were added, and the mixture was heated at 95°C for 1 hour. The mixture was then extracted with 1 mL of 1-butanol, and the absorbance of the extract was measured at 532 nm for the determination of TBA reactive substances (TBARS). A standard curve of 1,1,3,3-tetraethoxypropane was used to quantify the amount of the MDA produced [2]. The results thus obtained were compared to quercetin, gallic acid and marketed formulation Faceguard®.
Fig. 1: M. zapota extract impregnated disc
RESULTS AND DISCUSSION
The yeast test using Candida albicans as developed by Daniels is the most simple in vitro phototoxicity test. This test is based on a principle wherein the photo degraded products/metabolites of the phototoxic drugs formed as a result of UV exposure affects the growth of C. albicans.
However the photostabe drug does not yield any metabolites as such and hence the growth of C. albicans remains unaffected. Candida yeast test revealed that M. zapota leaves extract on irradiation did not produce any phototoxic compounds as shown in Figure 1 hence the growth of Candida albicans was not affected.
However the comparison standard, positive control psoralen containing Melanocyl® cream yielded phototoxic compounds on irradiation which affected the growth as shown in Figure 2. The C. albicans seeded agar plate served as negative control. The results thus indicate the photostability of the Manilkara zapota leaves extract.
Fig. 2: Positive control: Melanocyl®Cream impregnated disc.
Fig. 3: Negative control: Candida albicans seeded agar

Fig. 4: Spectra Measurement of the Extracts and Standards.
Further the UV Spectra measurement revealed that on irradiation the test sample i. e. Manilkara zapota leaves extract did not show a significant change in the absorption spectra particularly in the wavelength range 260-350 nm and the PABA sample was affected to a major extent in the wavelength range 260-300 nm as shown in the Fig. 4, indicating its photo instability. However, the benzophenone spectra remained unaffected indicating high photostability.
UVA radiation constitutes a very significant oxidative stress by causing peroxidation of lipids in biological systems [15]. Lipid peroxidation is a degenerative process, which affects the polyunsaturated fatty acids of membrane phospholipids. The general mechanism of this process involves the formation of toxic aldehydes such as MDA, a secondary product of lipid peroxidation, which react with protein and non-protein substances and result in widespread changes in cellular membranes. The reaction of lipid peroxides with TBA has been widely used as a sensitive method for determination of lipid peroxidation in animal tissues. Linoleic acid is one such fatty acid and linoleic acid hydroperoxide obtained by peroxidation reacts with TBA to yield the same red pigment as that obtained with MDA [2].
Photo labile drugs are known to cause lipid peroxidation in membrane lipids due to the degraded metabolites, leading to the formation of ROS in lipids. ROS is also one of the major causative factors for increased MDA formation. Thus measurement of the extent of such hydroperoxide formation with plain extract on exposure to UV radiation will provide a great input in determining the degree of photostability of the extracts. Linoleic acid lipid peroxidation test revealed that the extract on irradiation produced less MDA, a peroxidation product comparable to standards quercetin and gallic acid which are the effective flavonoids and polyphenols used as photo protective and antioxidant, indicative of its photostability.
The readings were also close to the marketed product Faceguard® containing photostable synthetic sunscreens, Uvinul A Plus (Diethylamino Hydroxybenzoyl Hexyl Benzoate), Tinosorb S (Bemotrinizol) and Octinoxate as shown in Table 1. The results also closely resemble the peroxidation prevented by lyophilized extracts of Sedium telephium leaves [16].
Table 1: Concentration of MDA formed.
| S. No. | Test Substance | Concentration of MDA formed (µmoles/ml) |
| 1 | Manilkara zapota leaves extract | 6.47±0.35 |
| 2 | Quercetin | 7.65±0.08 |
| 3 | Gallic acid | 6.88±0.19 |
| 4 | Faceguard® | 5.47±0.45 |
**P < 0.01with respect to photo irradiated linoleic acid
Thus the above findings provide valuable information on the photostability of the M. zapota extract. Preliminary phytochemical test using the hydroalcoholic extract obtained from M. zapota leaves revealed the presence of flavonoids and polyphenols to a major extent. These phytoconstituents could be responsible for exhibiting the antioxidant activity as reported in the literature [12, 7]. Flavonoids have been reviewed for wide biological activities due its capacity to interact with protein phosphorylation and the antioxidant, iron chelating and free-radical scavenging activity. Oxygen radicals are responsible for the deleterious effects of UVR upon the skin [17]. Thus flavonoids containing extracts like M. zapota leaves extract could be incorporated as a potential sunscreen agent to gain wide cosmetic utility.
CONCLUSION
In vitro photo-toxicity assays, indicative of the photostability of the Manilkara zapota extract revealed that the herbal extract was photostable and did not produce any photoirritant on irradiation. Present scenario in the cosmetic industry is customer focused and consumer acceptance as well as safety is the governing factor in the success of any product. Taking into consideration these very important requirements cosmetic researchers need to ensure the photostability of all the sunscreen agents. Hence In vitro photo-toxicity assays are the need of the hour so as to screen all dermal irritants prior marketing, thereby preventing the photosensitive skin reactions and exploring the photostable herbals as potential new generation sunscreens.
ACKNOWLEDGEMENT
The authors are thankful to Mr. Albert W. D’souza, Chairman, Aldel Education Trust and Dr. Savita J. Tauro, Principal, St. John Institute of Pharmacy and Research, Palghar for providing all the necessary facilities as well as magnanimous support throughout the research activity. We are grateful to the Management of the Institute and University of Mumbai for providing a financial support through Minor Research Grant to the author, Norma L. Rebello. We are also thankful to colleagues Pradeep Bawane, Galvina Pereira and Angel Godad and Arvind Naik for extending a helping hand in the research.
CONFLICT OF INTEREST
Nil.
REFERENCES
- Maithri S, Shetty S, George L, Mohan K. Evaluation of in vitro antioxidant property and radio Protective effect of the constituent medicinal plants of a herbal sunscreen formulations. Int J Pharm Frontier Res 2012;2(2); 90-6.
- Onoue S, Tsuda Y. Analytical studies on the prediction of photosensitive/phototoxic potential of pharmaceutical substances. Pharm Res 2006;23(1);156-64.
- Gordon JD, Andrew CC, Michael DC, Matherly C, Denison MS, Grune G, et al. Estrogenic potency of many popular sunscreens and its non-active components detected using the LUMI–CELLTM ER Bioassay. ISPAC–General, Dioxin, 2005;1145;2685-9.
- Safer AM, Al-Nughamish AJ. Hepatotoxicity induced by the anti-oxidant food additive, butylated hydroxy toluene (BHT), in rats: an electron microscopical study. Histol Histopathol 1999;14(2);391-406.
- Stolze K, Nohl H. Free radical formation and erythrocyte membrane alterations during methb formation induced by the BHA metabolite, terl-butyl hydroquinone (TBHQ). Free Radical Res 1999;30(4);295-303.
- Karim MR, Osman MA, Aziz MA, Habib MR. Antimicrobial Investigation on Manilkara zapota (L) P. Royen Int J Drug Dev Res 2011;3(1);185-90.
- Islam ME, Islam MR, Parvin MS, Islam MS, Hasan SM. Antioxidant activity of the ethanol extract of Manilkara zapota leaf. J Sci Res 2012;4(1);193-202.
- Seshadri S, Kothari V. In vitro antibacterial activity in seed extracts of Manilkara zapota, Anona squamosa, and Tamarindus indica. Biol Res 2010;43;165-8.
- Shivhare Y, Singh M. Manilkara zapota: An Overview. Herbal Tech Industry; 2011. p. 13-6.
- Shazly HA, Fayek NM, Monem AR, Mossa MY, Meselhy MR. Chemical and biological study of Manilkara zapota (L.) Van Royen leaves (Sapotaceae) cultivated in Egypt. Pharmacognosy Res 2012;4 (2);85–91.
- Shenoy P, Khot S, Chavan M, Takawale J, Singh S. Study of sunscreen activity of aqueous, methanol and acetone extracts of leaves of Pongamia pinnata (L.) Pierre, Fabaceae. Int J Green Pharm 2013. p. 217-24.
- Chanda SV, Nagani KV. Antioxidant capacity of Manilkara zapota L. leaves extracts evaluated by four in vitro methods. Nat Sci 2010;8(10);260-6.
- Rowe L, Norman J. Detection of phototoxic activity in plant specimens associated with primary photosensitization in livestock using a simple microbiological test. J Vet Diagn Invest 1989;1;269-70.
- Hojerova J, Medovcikova A, Mikula M. Photoprotective efficacy and photostability of fifteen sunscreen products having the same label SPF subjected to natural light. Int J Pharm 2011;408;27-38.
- Bose B, Chatterjee S. Correlation between UVA-induced changes in microviscosity, permeability and malondialdehyde formation in liposomal membrane. J Photochem Photobiol B: Biol 1995;28 (2);149-53.
- Bonina F, Puglia C, Tomaino A, Saija A, Mulinacci N, Romani A, et al. In vitro antioxidant and in vivo photo protective effect of three lyophilized extracts of Sedium telephium L. leaves. J Pharm Pharmacol 2010;52;1279-85.
- Bonina F, Lanza M, Montenegro L, Puglisi C, Tomaino A, Trombetta DA, et al. Flavonoids as potential protective agents against photo-oxidative skin damage. Int J Pharm 1996;145;87-94.